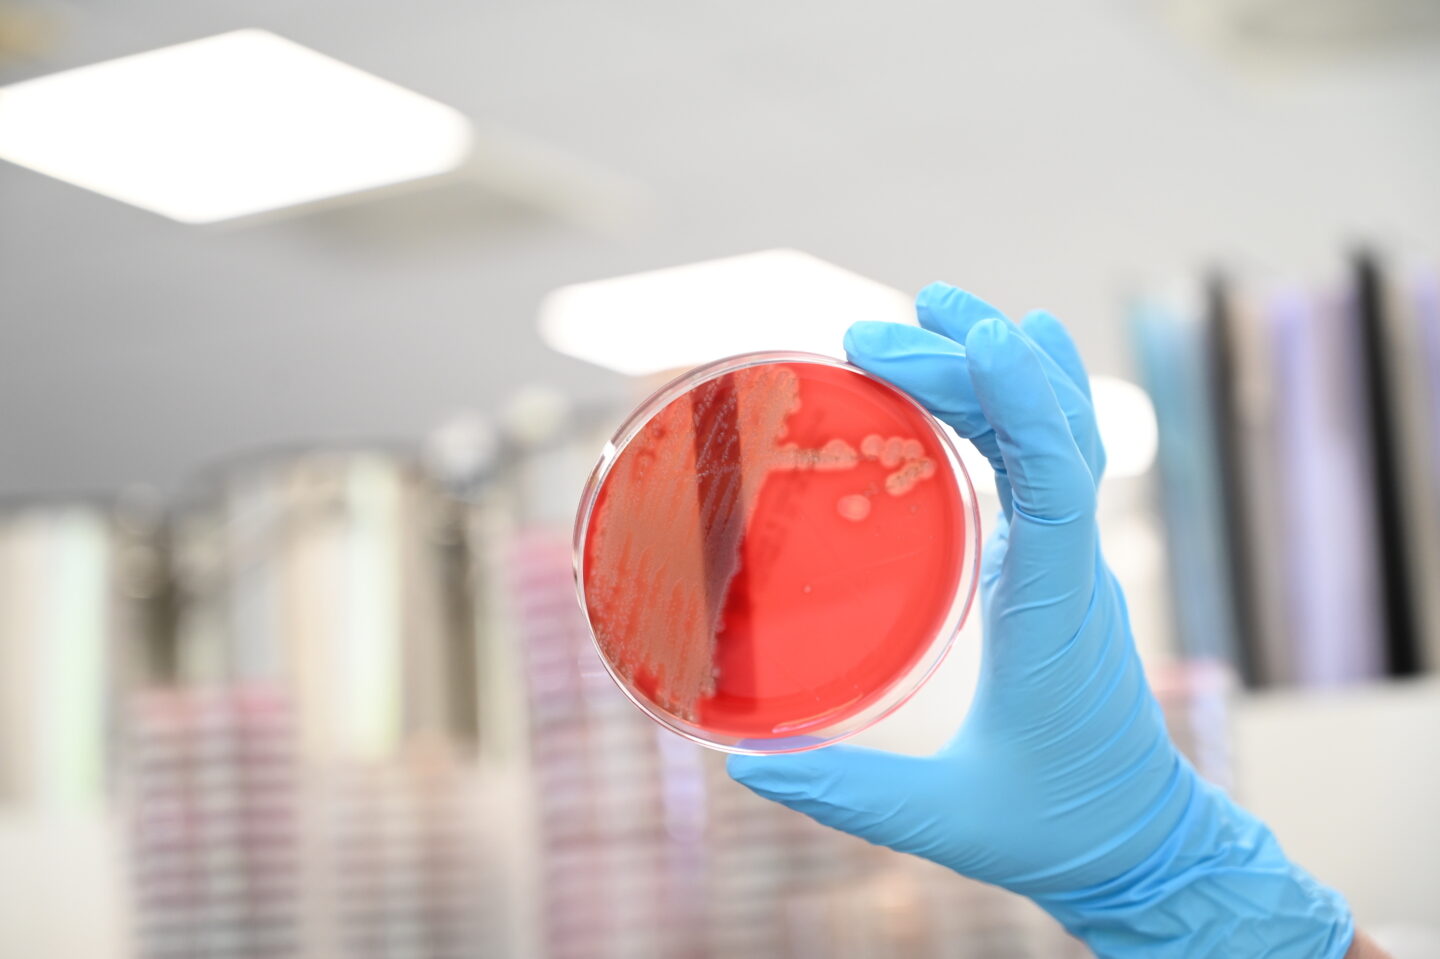

JUST4VETS +
Resistenzmonitoring beim Hund
Bakterielle Resistenzen stellen eine globale Bedrohung für Mensch und Tier und eine große Herausforderung für das gesamte Gesundheitswesen dar. Studien sagen einen deutlichen Anstieg der Todesfälle durch Infektionen mit resistenten Erregern voraus. Es werden vielfältige – durch die Regulierungsbehörden, die Wissenschaft, die Industrie und die Anwender von Antibiotika getragene – Anstrengungen unternommen, um die weitere Verbreitung bakterieller Resistenzen einzudämmen.
Wozu braucht man kumulierte Antibiogramme?
Die Anwendung kumulierter Antibiogramme ist in der Humanmedizin schon seit Jahrzehn